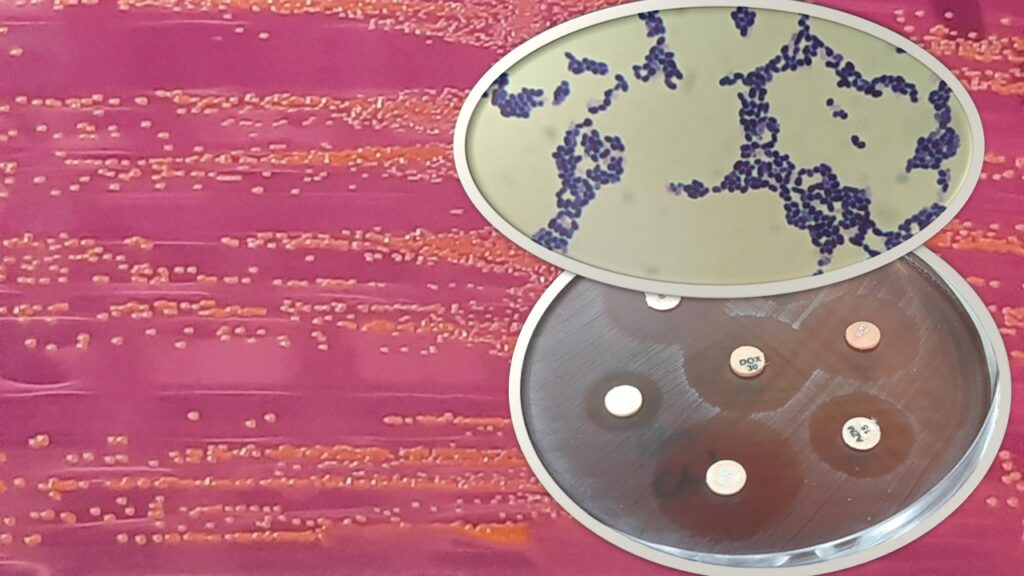
Lactococcus garvieae: Introduction, Pathogenicity, Lab Diagnosis, Treatment, Prevention, and Keynotes

Lactococcus garvieae: Introduction, Pathogenicity, Lab Diagnosis, Treatment, Prevention, and Keynotes
Introduction
Lactococcus garvieae is a Gram-positive, coccoid, facultative anaerobic bacterium causing lactococcosis, a major, often fatal, hemorrhagic septicemia in cultured fish (especially trout and yellowtail) when water temperatures exceed. As an emerging zoonotic pathogen, it causes sporadic, serious human infections (e.g., endocarditis).
- Classification: Family Streptococcaceae.
- Habitat: Ubiquitous; found in aquatic environments, fish, cattle (mastitis), and swine.
- Impact: Causes massive economic losses in aquaculture worldwide due to high mortality (up to 50%).
Pathogenicity
- Disease: Hyperacute and hemorrhagic septicemia.
- Clinical Signs in Fish: Exophthalmia (pop-eye), erratic swimming, darkening of skin, hemorrhage in the gills, fins, and anus.
- Virulence Factors: Capsules, hemolysins, adhesins (e.g., pav, psaA), superoxide dismutase, and biofilm formation.
- Transmission: Horizontal transmission via water, fecal-oral route, and contaminated feed.
Laboratory Diagnosis of Lactococcus garvieae
- Samples: Kidney, spleen, heart, blood, or brain tissue.
- Culture: Grows on Blood Agar (colonies are small, white, alpha-hemolytic) and specialized media.
- Biochemical: Gram-positive, Catalase-negative, -leucine-naphthylamide-positive.
- Molecular: PCR-based protocols, 16S rRNA gene sequencing, and RAPD for typing.
- Serotyping: Differentiation of pathogenic (capsulated) and non-pathogenic (non-capsulated) strains.
Treatment
- Antibiotics commonly used include florfenicol, amoxicillin, and erythromycin.
- Resistance: Increasing, with reports of resistance to tetracycline, streptomycin, and trimethoprim.
- Alternatives include phage therapy, probiotics, and, in some cases, herbal extracts.
Prevention
- Vaccination: Commercial and autogenous bacterins are effective, particularly in injection form.
- Husbandry: Lowering water temperature, reducing fish density, removing dead fish, and improving water quality.
Keynotes on Lactococcus garvieae
- Temperature Sensitivity: Outbreaks typically occur during warm summer months.
- Emerging Zoonosis: While historically a fish pathogen, it is now recognized to affect humans, usually elderly patients or those with underlying diseases.
- Host Range: Affects trout, tilapia, yellowtail, olive flounder, and occasionally, mammals.
- Dairy Association: Originally isolated from bovine mastitis.
Further Readings
- https://static-web.hipra.com/2025-06/poster1.pdf
- https://www.researchgate.net/publication/275330542_Lactococcus_garvieae_a_small_bacteria_and_a_big_data_world
- https://www.sciencedirect.com/science/article/abs/pii/S0147957106000312
- https://www.frontiersin.org/journals/microbiology/articles/10.3389/fmicb.2025.1610971/full
- https://pmc.ncbi.nlm.nih.gov/articles/PMC8473265
- https://afbi.dspacedirect.org/bitstreams/e78e123e-ae7a-48bd-966a-7c5b6d524c91/download
- https://pmc.ncbi.nlm.nih.gov/articles/PMC11858575
- https://www.mdpi.com/1422-0067/26/7/3423
- https://www.mdpi.com/2410-3888/9/10/406
- https://www.sciencedirect.com/science/article/pii/S0044848623011377
- https://www.mdpi.com/2076-2615/10/9/1609
[1193 visitors]
